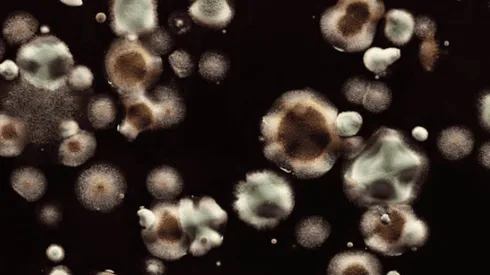
Candida Auris

Recientemente elMinisterio de Salud de Argentina confirmó dos casos de un extraño y contagioso hongo llamadoCandida auris.
¿Qué es la Candida Auris?
La Candida auris es un “superhongo” contagioso que normalmenteesadquiridoen hospitalespor pacientes consistemas inmunitarios debilitados.
Este hongopuede causar candidiasis invasiva (fungemia) en la que se infectan gravemente eltorrente sanguíneo, elsistema nervioso central y losórganosinternos de una persona.
Esta enfermedad es resistente a múltiples fármacos y el tratamiento es complejo, ya quesueleidentificarse erróneamente con otrasespecies deCandida.
Los síntomas de la infección con el hongo son:
- Fiebre
- Escalofríos
- El paciente no mejoradespués de tratamiento con antibiótico tras sospechar una infección bacteriana.
Cabe destacar que la Candida auris es potencialmente mortal yactualmente no existen vacunas.
¿Por qué es tan peligroso?
Este hongo es peligroso debido a que es multirresistente y debido a esto puede propagarse fácilmente y causar brotes en centros de atención médicos.
Según losCentros para el Control y Prevención de Enfermedades, se estima que más de uno de cada tres pacientes mueren dentro del primer mes de haber recibido el diagnóstico de una infección invasiva porCandida auris.
Además, este hongoes considerado comouno de los más peligrosos por laOrganización Mundial de la Salud (OMS).
¿Qué pasó en Argentina?
En Argentina se detectaron dos casos y uno de los contagiados es un paciente ingresado el 2 de octubre a una unidad de cuidados intensivos en una clínica local, quien había sido derivado de unaclínica del exterior del paísy queactualmente sigue internado.
El otro contagiadopresentó una fístula dedrenaje posquirúrgicayfue tratadode forma ambulatoria en la misma clínica, pero se precisó que no compartieron el mismo ámbito en el mismo momento de su estadía en la clínica, por lo que se confirmó que se mantiene unainvestigación epidemiológica.